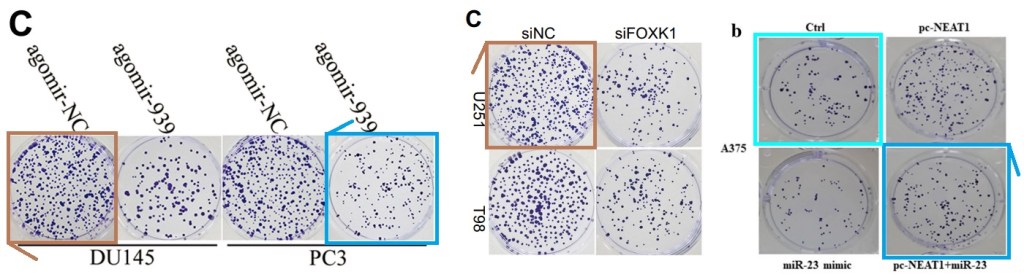

You may have heard about the classical Northern Renaissance art, but the modern art of Chinese papermills is still struggling to find its place in the canons of art history. Smut Clyde retraces the rich heritage of prodigious yet nameless Oriental masters who revolutionised scholarly publishing and biomedicine.
The spreadsheet is here, also as pdf:
And now, it’s the arts.

Target Practices
By Smut Clyde
For every Memling or Cranach¹ or Baldung Grien in Northern Renaissance² painting, there were many more artists whose names went unrecorded. They were mostly shite painters but they had served their apprenticeships and joined the Guild so they could wander around the Low Countries or the German states leaving a trail of altarpieces behind; and more to the point, they were shite in different ways. So every art historian’s dream is to spot the same stylistic mannerisms (artspeak for ‘way of being shite’) in three or four paintings from different locations, and announce that they were all the work of the same hand… a shadowy speculative figure who goes down in subsequent art histories as ‘The Master of the Madonna with Three Boobies’ or ‘The Master of the 11,000 Virgins’ or whatever. Papers are written reconstructing the Master’s influence and career, and forgers fill gaps in that career by ‘discovering’ new works in the Master’s style and selling them to self-taught collectors who know more than experts because they are rich.
All of this is an excuse to praise Leo Perutz’ great novel “Master of the Day of Judgment”. It is also a teaser, introducing my TED Talk on ‘The Master of the String-of-Sausages’. No-one asked for another post about Chinese papermills, but on the other hand, no-one specifically asked me not to write one either.
I begin in media res, in accordance with the precepts of Sophoclean tragedy. Ideally there would be a Greek Chorus to communicate plot twists in chanted strophes and antistrophes, but all I can offer are Transwell Assays and Western Blots and Colony-Formation plates.

There should also be a Deus ex Machina but the budget could only stretch to this:

The ‘Direct Target’ papermill was originally characterised by a large though not inexhaustible archive of flow-cytometry plots, each one a snapshot of cell-cycle phases within a population of cells, and sometimes used to illustrate two or even three papers by different ‘authors’. Presumably they were data from someone’s bona fide experiments — how they fell into the hands of the papermillers must remain a matter for conjecture. These plots remained within a confined gamut, and I imagine that someone who is wise in the ways of cytology could even identify the strain of domesticated cancer-cell used in the experiments. The millers later acquired a second stash of apoptosis plots, a second gamut, reminiscent of harps or amphorices.
Cell Cycle of Angry Axe-Wielding Tribbles
“For the most competitive papers, an ultra-rapid review (by members of the Editorial Board) is necessary to publish them a few days after submission.”, Misha Blagosklonny, on how his journals became papermill fraud bonanza
The underlying narrative of these papers was always the same: Non-coding RNA meets cell-signaling pathway, and it is love at first sight, despite the obstacles put in their path by researchers. The scriveners who assembled these adventures hewed as closely to their template as any professional romance-genre writer.

Recurring elements included a block of Transwell-assay and colony-formation-assay images at the end of each Act (Figures 2, 4 and 5, it might be) to quantify the authors’ claim that more or less of the ncRNA in question modulates the migratory or invasive or proliferative proclivities of that cancer cell-line.


Now it’s more a general guideline than a rule, but Transwell images should be unique. They should not share overlapping corners with images reported in unrelated studies, as if both were details from a single larger microphotograph, OOPS.


The generative, rule-driven nature of these romances made it easy to extend the list of examples, using PubMed’s “Similar papers” function, though much credit belongs to ImageTwin. By now the spreadsheet contains over 270 entries from 2016-2021, which is not enormously prolific by papermill standards but is still a respectable quantum of bullshit. A trail of continuity leads to newer, more-varied papers, mining new seams of Long non-coding RNAs, maybe the micro-RNA seam was exhausted?

These found good homes in increasingly up-market journals as the millers broadened their customer base and raised their ambitions… Aging is there, and Cell Cycle from Taylor & Francis, with 21 and 16 papers respectively. Cancer Medicine and Journal of Cellular Biochemistry represent Wiley. Cancer Cell International, Journal of Ovarian Research and Molecular Medicine represent Springer, and Gene and Pathology – Research and Practice for Elsevier.
The Adventures of a Mouse Malignancy Group Portraitist
Smut Clyde was busy with yet another Chinese paper mill. A plastic ruler was deployed.
13 examples in the now-moribund journal Oncology Research, from Cognizant Communications (who displayed their complaisance as hosts for the Traveling Tumor papermill). From Dove, Cancer Management and Research and OncoTargets and Therapy have been especially hospitable, with 27 and 30 papers respectively.

But the trail of continuity also leads backwards, for it turns out that the mill’s activities predated its acquisition of the flow-cytometry stockpile. In the initial stages of development (2016-2017), the millers exclusively worked the Spandidos side of the street, and productions were confined to the stable of Experimental and Therapeutic Medicine, International Journal of Molecular Medicine, International Journal of Oncology, Molecular Medicine Reports, Oncology Letters and Oncology Reports (13, 12, 8, 63, 14 and 26 papers respectively).

We have already encountered the Spandidos business partnerships with papermills. Demetrios Spandidos was an early adopter of the opportunities afforded by offering Chinese clinicians a way to adorn their CVs with fake publications (with the papermills providing the manuscripts, as the third leg of this Triple Détente of mutual benefit). One of these business partners operated out of the sprawl of hospitals affiliated to Jilin University, while a second was linked to a similar clinical empire of Xiangya hospitals surrounding Central South University. Both (I surmise) were realisations of an official policy of facilitating fake-paper mass-production. A single papermill collaboration could happen to anyone, two is just carelessness coincidence, but three…

At any rate, Spandidos rose to become the publisher of choice across China, while conversely, junk papers from China came to supply Spandidos journals with the preponderance of their content. But lists of disfavoured publishers are now circulating in Chinese academia, with Spandidos Press among those that are deprecated. It remains to be seen whether the company is still viable without that stream of content and publishing fees.
Spandidos and the Paper Mill
Papermills run by Chinese universities and funding a notorious Greek publisher. Smut Clyde tells it all!
The papers are coming from inside the house!
“It feels like half the higher-echelon professors at Jilin University have built their careers on these fairy-tales, with successions of papers itemising the interactions of ADAM10 or GRIM-19. […] if only they had published instead about the Tooth-Fairy circ-RNA and how it targets the Easter-Bunny Pathway…”, – Smut Clyde
Time now for more montages of chicken tracks Transwell images in their triplicate and quadruplicate profligacy!


Cancer Management and Research and OncoTargets and Therapy have largely purged their back-catalog of of these fabrications, for they are under new ownership: Taylor & Francis might not have realised the predatorial nature of Dove’s business model when they bought the company, but they are doing the best they can to salvage the asset. I add in the interests of scrupulous fairness that Spandidos editorial boards have also bitten the bullet³ and are retracting great swathes of Direct Target flimflam, in a steady trickle of depublication that includes the Jilin and CSU forgeries (if there were any justice, hundreds of aggrieved ‘authors’ would receive their money back from the papermills). That puts the ball in the Elsevier / Wiley / Springer court, or puts the hoses in their Augean Stable, but they show less interest in their part-ownership of the fraud.

The network of visual cross-links within this oeuvre is not limited to Transwell invasion / migration images. There are ‘travelling tumours’, though I will not dwell on the nomadic rulers (migrating between laboratories) that are a sine qua non of the papermill trade. That way lies madness, or at least an unhealthy obsession with rulers and their distinguishing marks and scratches.


Ruler of the Aging Papermill
Smut Clyde congratulates Aging: “This is bespoke tailoring, in contrast to the off-the-rack products cranked out by the average papermill […] no shame befalls the journals that accept these confections.”
The circumstantial details, adding verisimilitude to otherwise bald and unconvincing narratives, include these plates.

They are peppered with punctuation marks growing on nutrient gel… commas, full-stops, semi-colons, colons and even the occasional interrobang. This is why they are called ‘colony assays’ when used to quantify changes in cancer-cell proliferation. Used repeatedly, in fact, with some photoshop enhancement and customisation. If it is wrong to compare them with Lucio Fontana’s stabbed canvases then I don’t want to be right.

Of course these perforation proliferation plates are too visually persuasive to remain the hallmark of a single papermill. A second collection recurs across the corpus of a mill that operates out of Cangzhou University (judging from the number of clinical customers from Cangzhou hospitals) and works with Aging as its preferred partner journal. The ‘eyebrow papermill’ is a third proliferation-plate haven.


To muddy the water, there is some overlap between these papermill oeuvres. Sometimes (rarely), a proliferation image favoured by the Direct-Target crowd appears in a Cangzhou/Aging paper, or vice versa, so they are not infallible clues to classification. It may be that staff from one mill left to start their own company, taking visual archives with them, much as staff from the OMICS predatory-publishing scampire become rival parasitical publishers. Or perhaps they just steal from each other, or from the same ultimate sources. Anyway, I am reluctant to relinquish my careful taxonomy of the papermill industry.
The scientific sea of miR- and exosome-related knowledge
“Whole cohorts of peer-reviewers have been trained to view all these mannerist stylings as what western blots should look like. […] It will be a challenge to convince them otherwise.” – Smut Clyde.
‘Direct-Target’ products are further distinguished by a fondness for artisanal Western Blots, seemingly drawn with a broad-nib felt-pen, all string-of-sausages bands on a flat, featureless grey background.


This convention crystallised partway into the millers’ progress, and the WB calligraphy in their early Spandidos products is more flamboyant; they may even be genuine for all I know!
But is there one ‘Master of the String of Sausages’, or two? The ‘Contractor’ papermill went through its own phase of sausage-themed WBs, lasting roughly 2018-2020, having abandoned their cut-and-pasted Ransom-Note approach to WB generation, before moving on to the ‘ink-blobs’ and the ‘rows of bowties’ that characterises its current production. Again, Western Blot stylings are not infallible for purposes of classification.

Not even the prototypical flow-cytometry plots of the Direct-Target mill are 100% reliable as guides to provenance. Some recent manifestations might be second-generation frauds — copy-pasted from Directly Targeting products by rip-off rivals and interspersed with blatant fakes. It grieves me to report that there are unscrupulous actors in the industry, and some take so little pride in their work that they stoop to plundering material from colleagues.

Now drawing strings of sausages is not a difficult technical accomplishment, and the two mills might have converged on this style independently. But I am open to the possibility that they both outsourced their Western Blot production to a single, independent Wurst-Meister specialist. If it was good enough for Borges, it’s good enough for me.
- Cranach d.Ä and Cranach d.J. were shite draughtsmen too, but they churned out the portraits in such profusion that customers mistook their incompetence for the gold standard, and their names are recorded anyway.
- Anonymous Masters are less common in Southern European Renaissance art, on account of the popularity of celebrity gossip and the likes of Vasari dishing the dirt on their contemporaries.
- Do not ‘bite the bullet’ with live cartridges as detonation can be injurious to health.



Donate to Smut Clyde!
If you liked Smut Clyde’s work, you can leave here a small tip of 10 NZD (USD 7). Or several of small tips, just increase the amount as you like (2x=NZD 20; 5x=NZD 50). Your donation will go straight to Smut Clyde’s beer fund.
NZ$10.00




https://www.theguardian.com/world/2022/aug/11/china-overtakes-the-us-in-scientific-research-output
LikeLike
America must build its own papermill industry instead of relying on Chinese exports!
LikeLike
The problem is that you state the fact that any miRNA papers from China need to be considered with a lot of skepticism because of fraud, you will be called a racist by Average American Academics (triple AAA-haha) (eg the likes of Angela Rasmussen). If you state who you are, and make these statements of truth the twitter mob will end your career.
One could argue that in organic chemistry, Tomas Hudlicky was essentially shamed (literally) to death in this manner, for making politically incorrect statements (including holding Chinese chemistry papers suspect) that he published (or tied to publish). IMO, if his statements are read carefully, they were not all-together unreasonable.
LikeLike
Pingback: Proposta di riforma – ocasapiens